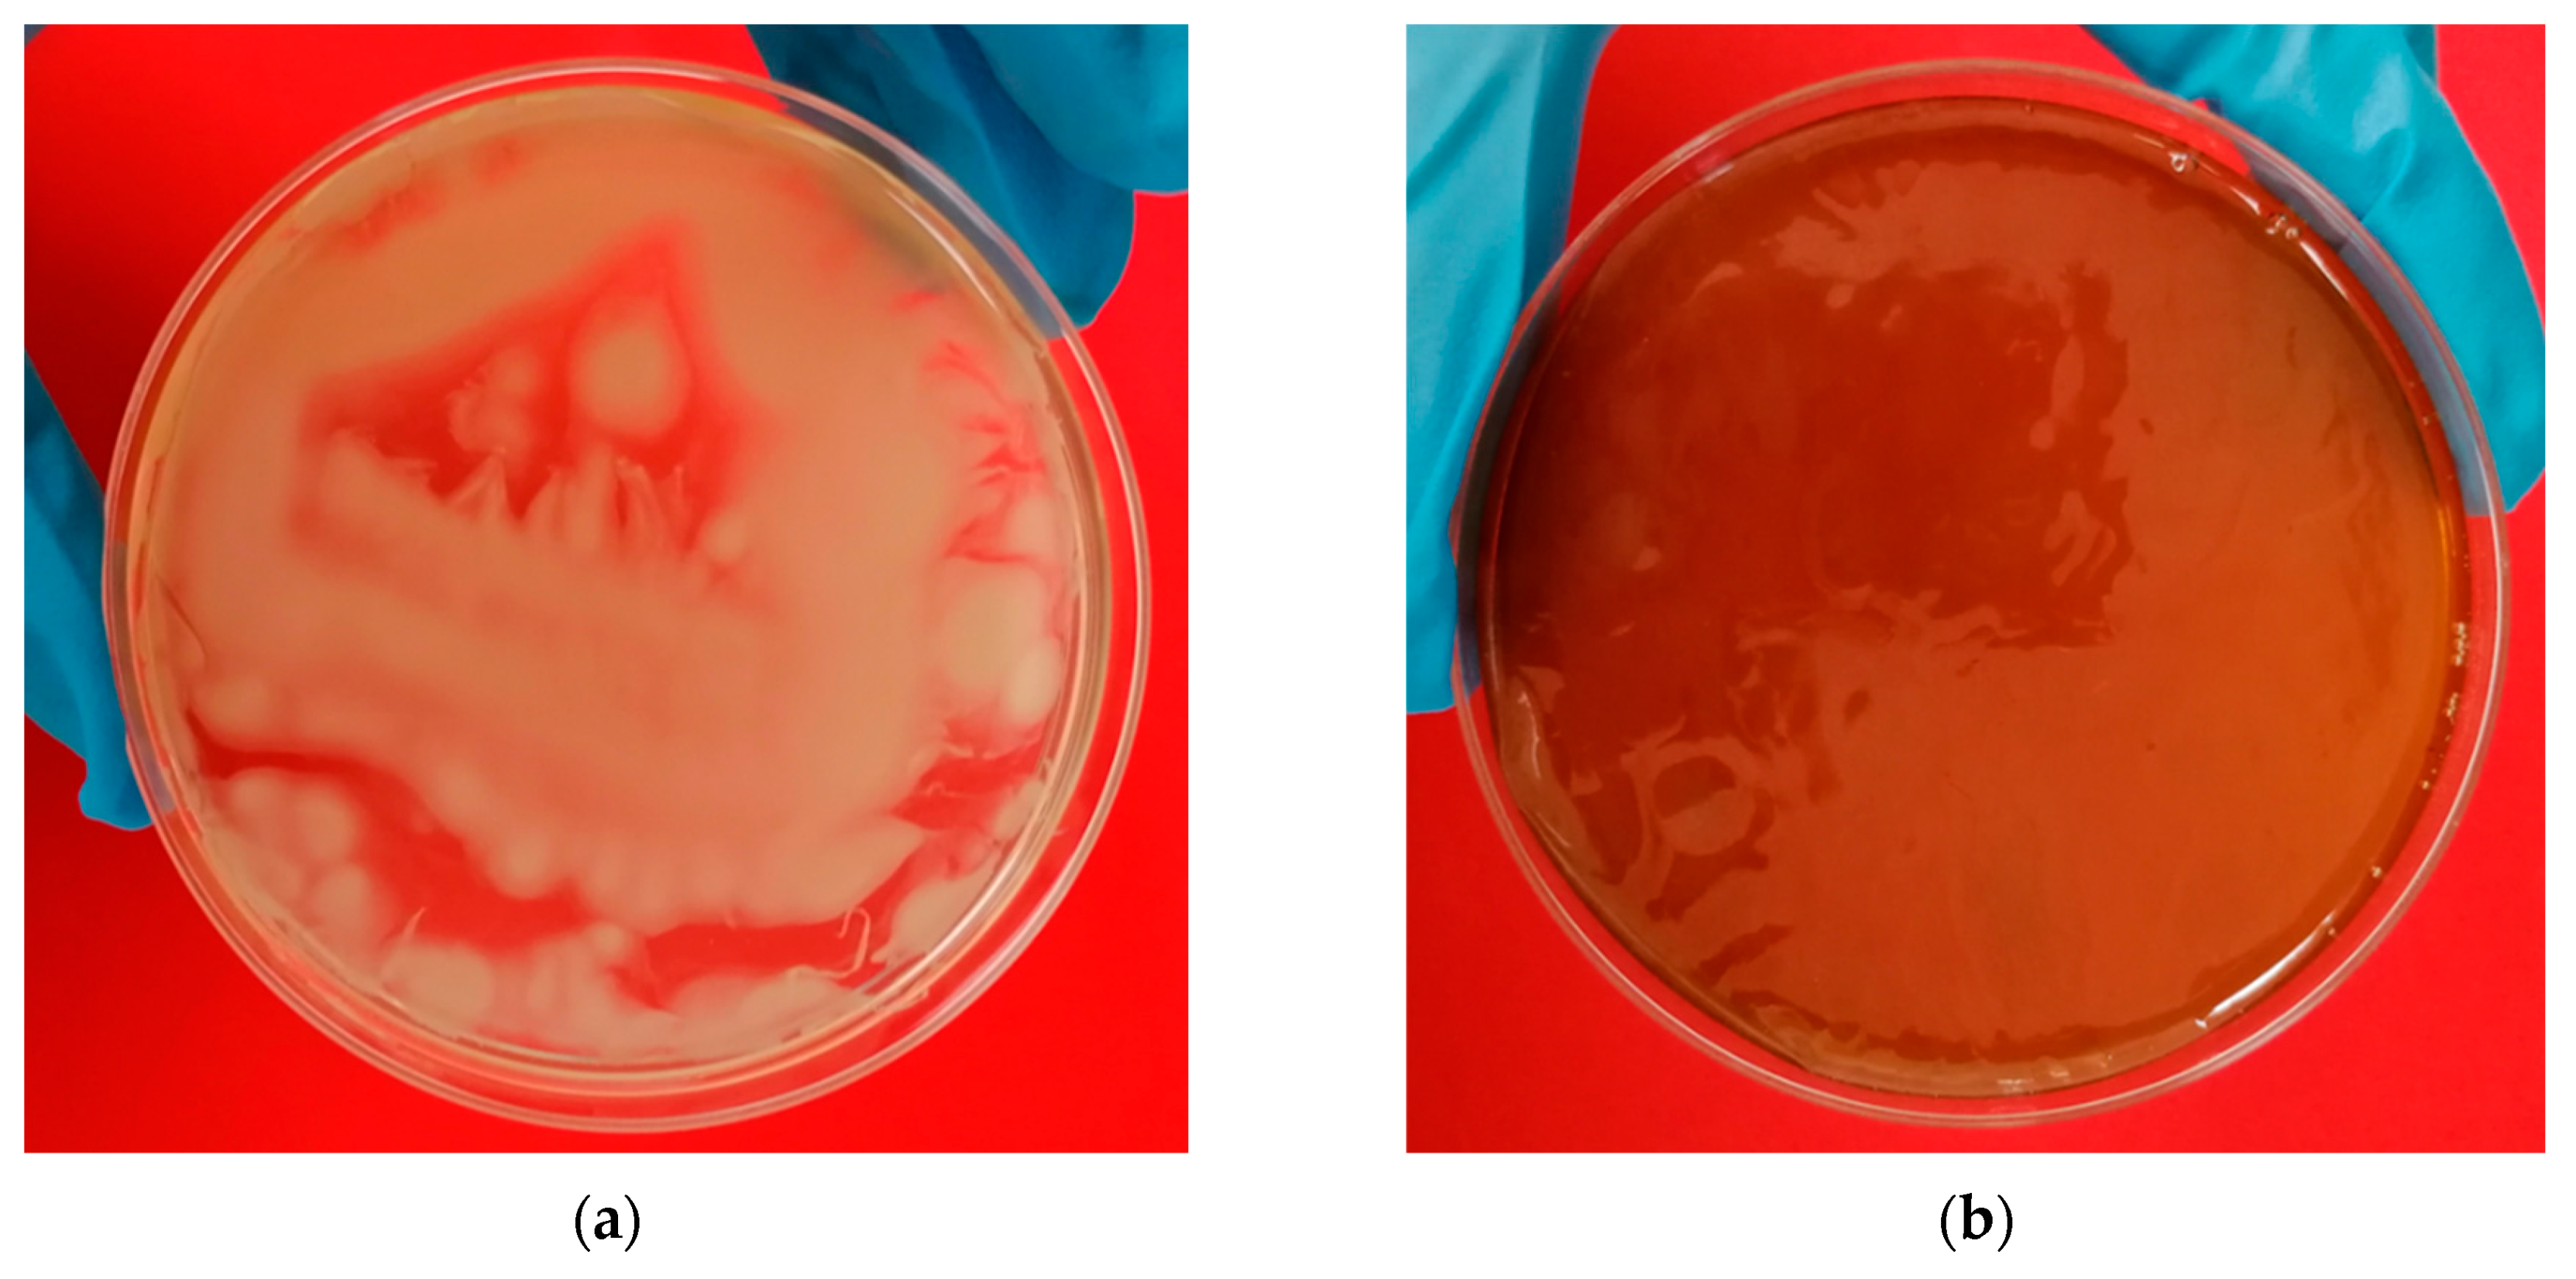
Polymers 14 05194 g003

Production and Characterization of Active Bacterial Cellulose Films Obtained from the Fermentation of Wine Bagasse and Discarded Potatoes by Komagateibacter xylinus
Abstract
:1. Introduction
2. Materials and Methods
2.1. Chemicals and Standards
2.2. Culture Media for Bacterial Cellulose Synthesis
2.3. Bacterial Cellulose Fermentation
- -
- The pH was measured using pHmeter pH 210 (Hanna Instruments, Woonsocket, RI, USA).
- -
- The drained weight (g) was determined from the weight of the samples of BC, from which excess liquid was removed by draining the BC for 1 h.
- -
- The dry weight (g) of the BC was determined from samples dried at 105 °C for 24 h.
- -
- The swelling capacity (%S) of the polysaccharides was calculated from the difference in the drained weight and the dry weight of the polymer matrix.
- -
- BC concentration (g/L) was calculated by considering the amount of BC synthesized (dry weight, g) per unit of volume of the culture medium in each Petri dish (25 mL).
- -
2.4. Analytical Methods
2.5. Bacterial Cellulose Films Processing
2.6. Characterization of the Antioxidant Bacterial Cellulose Samples as Films
2.7. Statistical Analysis
3. Results and Discussion
3.1. Bacterial Cellulose Production
3.2. Characterization of Bacterial Cellulose Films
4. Conclusions
Author Contributions
Funding
Institutional Review Board Statement
Data Availability Statement
Acknowledgments
Conflicts of Interest
References
- Otoni, C.G.; Azeredo, H.M.C.; Mattos, B.D.; Beaumont, M.; Correa, D.S.; Rojas, O.J. The Food–Materials Nexus: Next Generation Bioplastics and Advanced Materials from Agri-Food Residues. Adv. Mater. 2021, 33, 2170342. [Google Scholar] [CrossRef]
- Kovalcik, A.; Pernicova, I.; Obruca, S.; Szotkowski, M.; Enev, V.; Kalina, M.; Marova, I. Grape Winery Waste as a Promising Feedstock for the Production of Polyhydroxyalkanoates and Other Value-Added Products. Food Bioprod. Process. 2020, 124, 1–10. [Google Scholar] [CrossRef]
- Hussain, Z.; Sajjad, W.; Khan, T.; Wahid, F. Production of Bacterial Cellulose from Industrial Wastes: A Review. Cellulose 2019, 1, 2895–2911. [Google Scholar] [CrossRef]
- Cazon, P.; Velázquez, G.; Vázquez, M. Bacterial Cellulose Films: Evaluation of the Water Interaction. Food Packag. Shelf Life 2020, 25, 100526. [Google Scholar] [CrossRef]
- Picheth, G.F.; Pirich, C.L.; Sierakowski, M.R.; Woehl, M.A.; Sakakibara, C.N.; de Souza, C.F.; Martin, A.A.; da Silva, R.; de Freitas, R.A. Bacterial Cellulose in Biomedical Applications: A Review. Int. J. Biol. Macromol. 2017, 104, 97–106. [Google Scholar] [CrossRef]
- Ullah, H.; Santos, H.A.; Khan, T. Applications of Bacterial Cellulose in Food, Cosmetics and Drug Delivery. Cellulose 2016, 23, 2291–2314. [Google Scholar] [CrossRef]
- Cazón, P.; Vázquez, M. Bacterial Cellulose as a Biodegradable Food Packaging Material: A Review. Food Hydrocoll. 2021, 113, 106530. [Google Scholar] [CrossRef]
- Torres, F.G.; Troncoso, O.P.; Gonzales, K.N.; Sari, R.M.; Gea, S. Bacterial Cellulose-based Biosensors. Med. Devices Sens. 2020, 3, e10102. [Google Scholar] [CrossRef]
- Portilla Rivera, O.M.; Saavedra Leos, M.D.; Solis, V.E.; Domínguez, J.M. Recent Trends on the Valorization of Winemaking Industry Wastes. Curr. Opin. Green Sustain. Chem. 2021, 27, 100415. [Google Scholar] [CrossRef]
- Cerrutti, P.; Roldán, P.; García, R.M.; Galvagno, M.A.; Vázquez, A.; Foresti, M.L. Production of Bacterial Nanocellulose from Wine Industry Residues: Importance of Fermentation Time on Pellicle Characteristics. J. Appl. Polym. Sci. 2016, 133, 43109. [Google Scholar] [CrossRef]
- Carreira, P.; Mendes, J.A.S.; Trovatti, E.; Serafim, L.S.; Freire, C.S.R.; Silvestre, A.J.D.; Neto, C.P. Utilization of Residues from Agro-Forest Industries in the Production of High Value Bacterial Cellulose. Bioresour. Technol. 2011, 102, 7354–7360. [Google Scholar] [CrossRef]
- Ogrizek, L.; Lamovšek, J.; Čuš, F.; Leskovšek, M.; Gorjanc, M. Properties of Bacterial Cellulose Produced Using White and Red Grape Bagasse as a Nutrient Source. Processes 2021, 9, 1088. [Google Scholar] [CrossRef]
- Rani, M.U.; Udayasankar, K.; Appaiah, K.A.A. Properties of Bacterial Cellulose Produced in Grape Medium by Native Isolate Gluconacetobacter sp. J. Appl. Polym. Sci. 2011, 120, 2835–2841. [Google Scholar] [CrossRef]
- Wu, D. Recycle Technology for Potato Peel Waste Processing: A Review. Procedia Environ. Sci. 2016, 31, 103–107. [Google Scholar] [CrossRef] [Green Version]
- Maroušek, J.; Rowland, Z.; Valášková, K.; Král, P. Techno-Economic Assessment of Potato Waste Management in Developing Economies. Clean Technol. Environ. Policy 2020, 22, 937–944. [Google Scholar] [CrossRef]
- Guerra-Rodríguez, E.; Portilla-Rivera, O.M.; Ramírez, J.A.; Vázquez, M. Modelling of the Acid Hydrolysis of Potato (Solanum Tuberosum) for Fermentative Purposes. Biomass Bioenergy 2012, 42, 59–68. [Google Scholar] [CrossRef]
- Kot, A.M.; Pobiega, K.; Piwowarek, K.; Kieliszek, M.; Błażejak, S.; Gniewosz, M.; Lipińska, E. Biotechnological Methods of Management and Utilization of Potato Industry Waste—A Review. Potato Res. 2020, 63, 431–447. [Google Scholar] [CrossRef]
- Abdelraof, M.; Hasanin, M.S.; El-Saied, H. Ecofriendly Green Conversion of Potato Peel Wastes to High Productivity Bacterial Cellulose. Carbohydr. Polym. 2019, 211, 75–83. [Google Scholar] [CrossRef]
- Vazquez, M.; Martin, A.M. Mathematical Model for Phaþia Rhodozyma Growth Using Peat Hydrolysates as Substrate. J. Sci. Food Agric. 1998, 76, 481–487. [Google Scholar] [CrossRef]
- Salari, M.; Sowti Khiabani, M.; Rezaei Mokarram, R.; Ghanbarzadeh, B.; Samadi Kafil, H. Preparation and Characterization of Cellulose Nanocrystals from Bacterial Cellulose Produced in Sugar Beet Molasses and Cheese Whey Media. Int. J. Biol. Macromol. 2019, 122, 280–288. [Google Scholar] [CrossRef]
- Kuo, C.-H.; Teng, H.-Y.; Lee, C.-K. Knock-out of Glucose Dehydrogenase Gene in Gluconacetobacter Xylinus for Bacterial Cellulose Production Enhancement. Biotechnol. Bioprocess. Eng. 2015, 20, 18–25. [Google Scholar] [CrossRef]
- Singh, O.V.; Singh, R.P. Bioconversion of Grape Must into Modulated Gluconic Acid Production by Aspergillus Niger ORS-4·410. J. Appl. Microbiol. 2006, 100, 1114–1122. [Google Scholar] [CrossRef] [PubMed]
- Guerra-Rodríguez, E.; Portilla-Rivera, O.M.; Jarquín-Enríquez, L.; Ramírez, J.A.; Vázquez, M. Acid Hydrolysis of Wheat Straw: A Kinetic Study. Biomass Bioenergy 2012, 36, 346–355. [Google Scholar] [CrossRef]
- Flórez, M.; Cazón, P.; Vázquez, M. Active Packaging Film of Chitosan and Santalum Album Essential Oil: Characterization and Application as Butter Sachet to Retard Lipid Oxidation. Food Packag. Shelf Life 2022, 34, 100938. [Google Scholar] [CrossRef]
- Flórez, M.; Cazón, P.; Vázquez, M. Antioxidant Extracts of Nettle (Urtica Dioica) Leaves: Evaluation of Extraction Techniques and Solvents. Molecules 2022, 27, 6015. [Google Scholar] [CrossRef]
- Cazón, P.; Vázquez, M.; Velazquez, G. Composite Films with UV-Barrier Properties Based on Bacterial Cellulose Combined with Chitosan and Poly(Vinyl Alcohol): Study of Puncture and Water Interaction Properties. Biomacromolecules 2019, 20, 2084–2095. [Google Scholar] [CrossRef]
- Cazon, P.; Vazquez, M.; Velazquez, G. Composite Films of Regenerate Cellulose with Chitosan and Polyvinyl Alcohol: Evaluation of Water Adsorption, Mechanical and Optical Properties. Int. J. Biol. Macromol. 2018, 117, 235–246. [Google Scholar] [CrossRef]
- Cazón, P.; Velázquez, G.; Vázquez, M. Characterization of Bacterial Cellulose Films Combined with Chitosan and Polyvinyl Alcohol: Evaluation of Mechanical and Barrier Properties. Carbohydr. Polym. 2019, 216, 72–85. [Google Scholar] [CrossRef]
- Cazon, P.; Velázquez, G.; Vázquez, M. UV-Protecting Films Based on Bacterial Cellulose, Glycerol and Polyvinyl Alcohol: Effect of Water Activity on Barrier, Mechanical and Optical Properties. Cellulose 2020, 27, 8199–8213. [Google Scholar] [CrossRef]
- González-Centeno, M.R.; Rosselló, C.; Simal, S.; Garau, M.C.; López, F.; Femenia, A. Physico-Chemical Properties of Cell Wall Materials Obtained from Ten Grape Varieties and Their Byproducts: Grape Pomaces and Stems. LWT Food Sci. Technol. 2010, 43, 1580–1586. [Google Scholar] [CrossRef]
- Spigno, G.; Tramelli, L.; De Faveri, D.M. Effects of Extraction Time, Temperature and Solvent on Concentration and Antioxidant Activity of Grape Marc Phenolics. J. Food Eng. 2007, 81, 200–208. [Google Scholar] [CrossRef]
- Martelo-Vidal, M.J.; Vázquez, M. Determination of Polyphenolic Compounds of Red Wines by UV-VIS-NIR Spectroscopy and Chemometrics Tools. Food Chem. 2014, 158, 28–34. [Google Scholar] [CrossRef]
- Keshk, S. Vitamin C Enhances Bacterial Cellulose Production in Gluconacetobacter Xylinus. Carbohydr. Polym. 2014, 99, 98–100. [Google Scholar] [CrossRef]
- Lin, S.P.; Loira Calvar, I.; Catchmark, J.M.; Liu, J.R.; Demirci, A.; Cheng, K.C. Biosynthesis, Production and Applications of Bacterial Cellulose. Cellulose 2013, 20, 2191–2219. [Google Scholar] [CrossRef]
- Reiniati, I.; Hrymak, A.N.; Margaritis, A. Recent Developments in the Production and Applications of Bacterial Cellulose Fibers and Nanocrystals. Crit. Rev. Biotechnol. 2017, 37, 510–524. [Google Scholar] [CrossRef]
- Keshk, S.; Sameshima, K. Influence of Lignosulfonate on Crystal Structure and Productivity of Bacterial Cellulose in a Static Culture. Enzym. Microb. Technol. 2006, 40, 4–8. [Google Scholar] [CrossRef]
- Zhao, Y.; Wu, B.; Yan, B.; Gao, P. Mechanism of Cellobiose Inhibition in Cellulose Hydrolysis by Cellobiohydrolase. Sci. China Ser. C Life Sci. 2004, 47, 18–24. [Google Scholar] [CrossRef]
- Yedro, F.M.; García-Serna, J.; Cantero, D.A.; Sobrón, F.; Cocero, M.J. Hydrothermal Fractionation of Grape Seeds in Subcritical Water to Produce Oil Extract, Sugars and Lignin. Catal. Today 2015, 257, 160–168. [Google Scholar] [CrossRef]
- Kim, H.; Son, J.; Lee, J.; Yoo, H.Y.; Lee, T.; Jang, M.; Oh, J.M.; Park, C. Improved Production of Bacterial Cellulose through Investigation of Effects of Inhibitory Compounds from Lignocellulosic Hydrolysates. GCB Bioenergy 2021, 13, 436–444. [Google Scholar] [CrossRef]
- Dayal, M.S.; Catchmark, J.M. Mechanical and Structural Property Analysis of Bacterial Cellulose Composites. Carbohydr. Polym. 2016, 144, 447–453. [Google Scholar] [CrossRef]
- Cazon, P.; Velazquez, G.; Ramírez, J.A.; Vázquez, M. Polysaccharide-Based Films and Coatings for Food Packaging: A Review. Food Hydrocoll. 2017, 68, 136–148. [Google Scholar] [CrossRef]
- Lin, S.-B.; Hsu, C.-P.; Chen, L.-C.; Chen, H.-H. Adding Enzymatically Modified Gelatin to Enhance the Rehydration Abilities and Mechanical Properties of Bacterial Cellulose. Food Hydrocoll. 2009, 23, 2195–2203. [Google Scholar] [CrossRef]

| Time | pH | Drained Weight | Dried Weight | BC | BC %S | Gluconic Acid |
|---|---|---|---|---|---|---|
| Day | g | g | g/L | % | g/L | |
| 0 | 5.20 ± 0.01 a | - | - | - | - | 6.49 ± 0.19 a |
| 2 | 4.68 ± 0.11 b | 0.48 ± 0.15 a | 0.01 ± 1.18 × 10−3 a | 0.23 ± 0.05 a | 8611 ± 3001 abe | 9.43 ± 0.74 b |
| 3 | 3.57 ± 0.04 cd | 2.15 ± 0.10 b | 0.02 ± 2.73 × 10−3 a | 0.67 ± 0.11 a | 12,935 ± 2551 a | 24.42 ± 1.47 c |
| 4 | 3.46 ± 0.01 c | 3.02 ± 0.14 bc | 0.041 ± 4.01 × 10−3 a | 1.64 ± 0.16 ae | 7318 ± 745 bc | 24.72 ± 0.33 c |
| 5 | 3.50 ± 0.01 cd | 3.23 ± 0.50 bc | 0.09 ± 0.02 b | 3.66 ± 0.75 b | 3463 ± 419 c | 22.39 ± 0.43 c |
| 6 | 3.55 ± 0.01 cde | 3.71 ± 0.19 ce | 0.10 ± 0.01 b | 4.00 ± 0.49 b | 3640 ± 393 c | 19.47 ± 1.22 d |
| 7 | 3.58 ± 0.01 bde | 4.69 ± 0.56 ef | 0.08 ± 0.01 b | 3.10 ± 0.33 bce | 5952 ± 217 ec | 15.79 ± 0.96 e |
| 8 | 3.64 ± 0.05 bef | 4.80 ± 0.41 ef | 0.11 ± 0.03 b | 4.32 ± 1.07 bc | 4615 ± 1646 ec | 13.36 ± 1.19 f |
| 9 | 3.70 ± 0.05 bf | 5.18 ± 0.20 f | 0.10 ± 0.01 b | 4.14 ± 0.48 b | 4963 ± 722 ec | 12.00 ± 0.82 fg |
| 10 | 3.80 ± 0.05 | 5.28 ± 0.76 f | 0.09 ± 0.01 b | 3.71 ± 0.30 b | 5658 ± 1276 ec | 9.86 ± 1.32 g |
| Time | pH | Drained Weight | Dried Weight | BC Concentration | BC %S | Gluconic Acid |
|---|---|---|---|---|---|---|
| Day | g | g | g/L | % | g/L | |
| 0 | 5.26 ± 0.01 a | - | - | - | - | 0.98 ± 0.15 a |
| 2 | 3.25 ± 0.03 bd | 2.47 ± 0.48 a | 0.009 ± 0.001 | 0.35 ± 0.02 a | 28,169 ± 4038 a | 11.95 ± 0.28 b |
| 3 | 3.17 ± 0.01 c | 2.71 ± 0.20 a | 0.010 ± 3.06 × 10−4 | 0.41 ± 0.01 a | 26,592 ± 1306 a | 15.40 ± 0.33 c |
| 4 | 3.17 ± 0.01 c | 2.61 ± 0.40 a | 0.010 ± 0.002 | 0.41 ± 0.07 a | 25,471 ± 1249 a | 14.53 ± 0.20 c |
| 5 | 3.15 ± 0.02 c | 2.29 ± 0.50 a | 0.011 ± 0.001 | 0.43 ± 0.05 a | 20,948 ± 4246 abc | 12.72 ± 0.31 b |
| 6 | 3.18 ± 0.02 bc | 2.61 ± 0.21 b | 0.020 ± 0.003 | 0.78 ± 0.13 b | 13,352 ± 1487 bc | 10.08 ± 0.93 d |
| 7 | 3.27 ± 0.01 d | 2.71 ± 0.55 a | 0.012 ± 0.004 | 047 ± 0.14 a | 22,496 ± 2653 abc | 7.88 ± 0.67 e |
| 8 | 3.27 ± 0.03 d | 2.65 ± 0.04 ab | 0.014 ± 0.004 | 0.54 ± 0.17 a | 20,787 ± 5874 ac | 6.11 ± 0.80 f |
| 9 | 3.35 ± 0.06 e | 2.39 ± 0.87 a | 0.011 ± 0.0031 | 0.44 ± 0.10 a | 21,205 ± 2961 a | 4.57 ± 0.36 g |
| 10 | 3.42 ± 0.02 f | 2.09 ± 0.44 ab | 0.013 ± 0.001 | 0.52 ± 0.02 a | 16,100 ± 3956 c | 3.61 ± 0.14 h |
| Property | Value | Unit |
|---|---|---|
| Thickness | 0.010 ± 0.001 | mm |
| Tensile strength | 22.77 ± 2.54 | MPa |
| Percentage of elongation | 1.65 ± 0.43 | % |
| Young’s Modulus | 910.46 ± 48.66 | MPa |
| Burst strength | 159.31 ± 47.99 | g |
| Distance to burst | 0.70 ± 0.14 | mm |
| Water vapor permeability | 3.40 × 10−12 ± 1.35 × 10−13 | g/m·s·Pa |
| %W * | 10.07 ± 1.55 | % |
| Swelling capacity | 1053.27 ± 45.59 | % |
Publisher’s Note: MDPI stays neutral with regard to jurisdictional claims in published maps and institutional affiliations. |
© 2022 by the authors. Licensee MDPI, Basel, Switzerland. This article is an open access article distributed under the terms and conditions of the Creative Commons Attribution (CC BY) license (https://creativecommons.org/licenses/by/4.0/).
Share and Cite
Cazón, P.; Puertas, G.; Vázquez, M. Production and Characterization of Active Bacterial Cellulose Films Obtained from the Fermentation of Wine Bagasse and Discarded Potatoes by Komagateibacter xylinus. Polymers 2022, 14, 5194. https://doi.org/10.3390/polym14235194
Cazón P, Puertas G, Vázquez M. Production and Characterization of Active Bacterial Cellulose Films Obtained from the Fermentation of Wine Bagasse and Discarded Potatoes by Komagateibacter xylinus. Polymers. 2022; 14(23):5194. https://doi.org/10.3390/polym14235194
Chicago/Turabian StyleCazón, Patricia, Gema Puertas, and Manuel Vázquez. 2022. "Production and Characterization of Active Bacterial Cellulose Films Obtained from the Fermentation of Wine Bagasse and Discarded Potatoes by Komagateibacter xylinus" Polymers 14, no. 23: 5194. https://doi.org/10.3390/polym14235194





